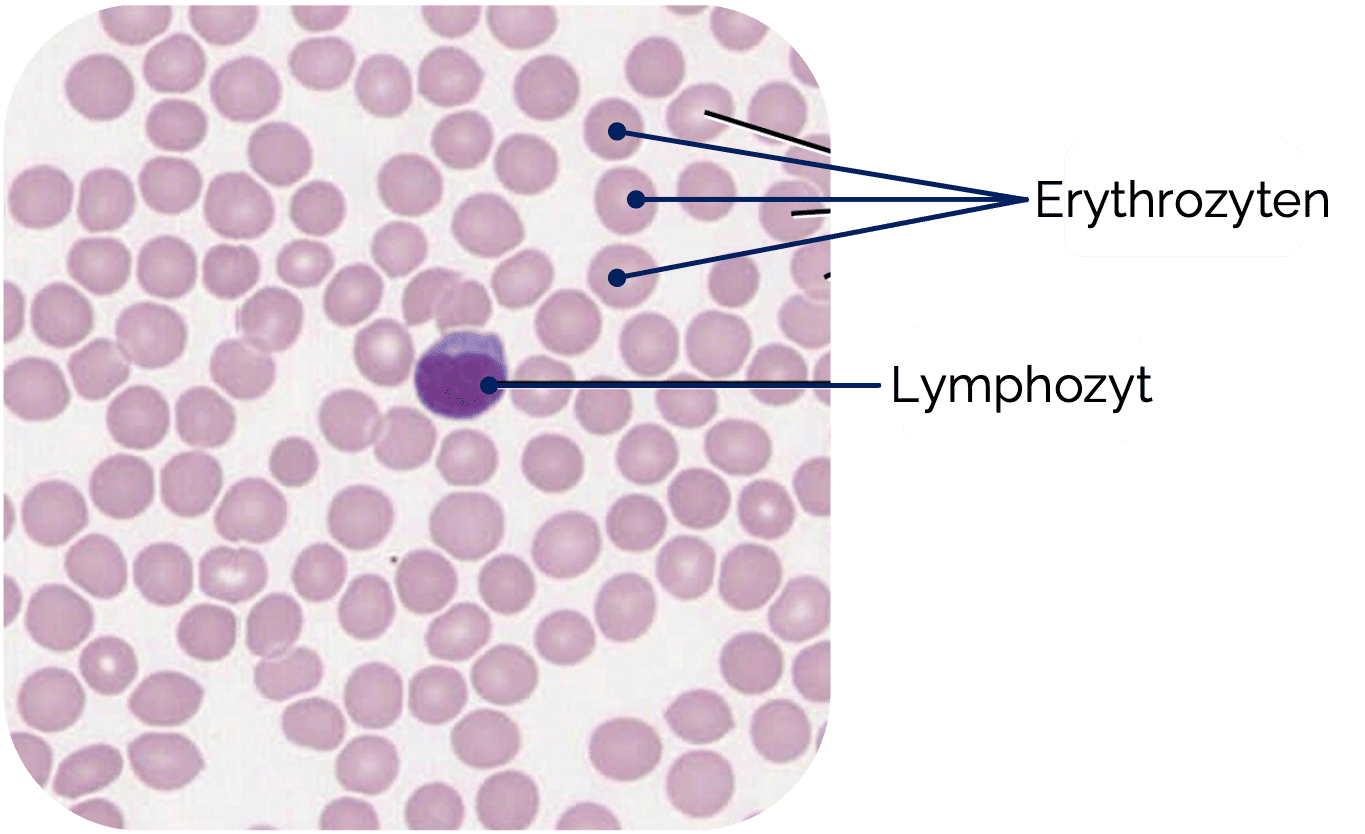
Erythrozyt

Erythrozyten
Die Erythrozyten
Die Erythrozyten
- Hauptbestandteil: Hämoglobin
- Bindung und Transport von Sauerstoff
und Kohlenstoffdioxid
- Bindung und Transport von Sauerstoff
- Form
- Bikonkave Scheibenform (beidseitig eingedellt)
- Im Blutausstrich: runde Scheibe mit zentraler Aufhellung
- Elastisch verformbar, passieren auch enge Kapillaren
- Zytoskelett
- Besteht aus Spektrin und Aktin
- Bildung eines netzartigen Membranskeletts
- Verankerung an Transmembranproteinen über Ankyrin und Protein 4.1
- Alterung
- Verlust der Membranflexibilität
- Abbau in Milz, Leber
und Knochenmark
- Glykokalix
- Träger der Blutgruppenantigene
OpenStax College, CC BY 3.0 <https://creativecommons.org/licenses/by/3.0>, via Wikimedia Commons
